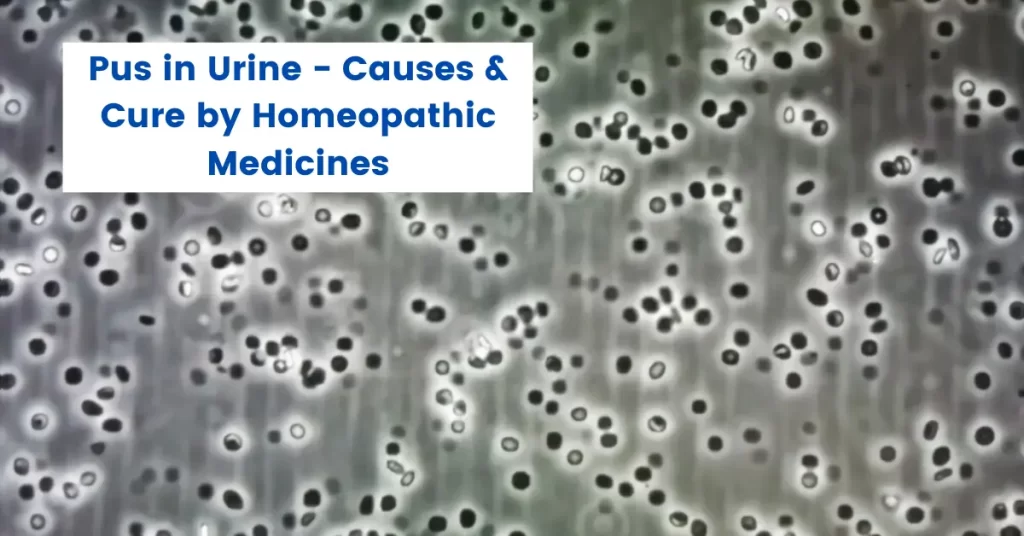
Pus in Urine Treatment - Causes and Homeopathy Medicines

Rash Behind Ear – Causes & Treatment by Homeopathy Medicines
A rash behind ear can be an uncomfortable and sometimes embarrassing condition. It is a skin irritation that can occur due to a variety of causes, including infections, allergies, and skin conditions. The symptoms of a rash behind the ear may include redness, itching, blistering, and scaling. In some cases, the rash may be accompanied […]
Rash Behind Ear – Causes & Treatment by Homeopathy Medicines Read More »